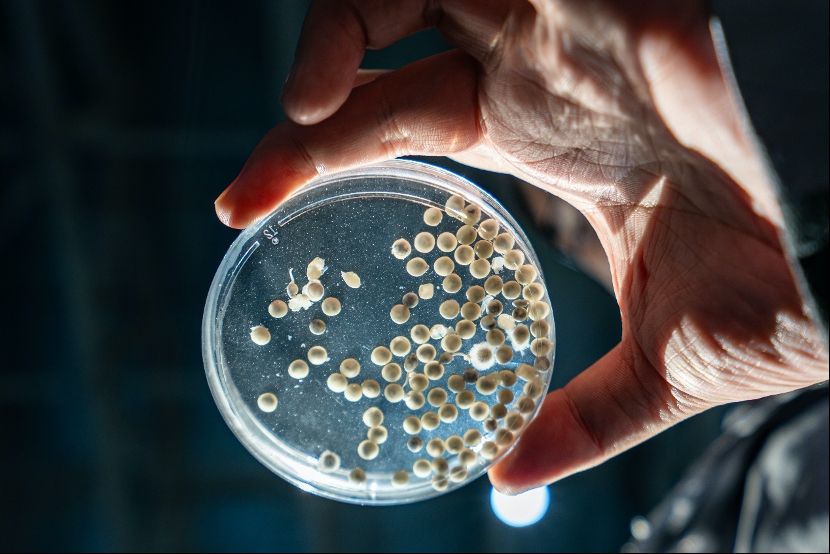

本网讯(谢泽)中华鲟,是陪伴中华民族母亲河长江亿万年的生物“活化石”,也是在全世界现代工业文明进程中一度陷入生存危境的物种之一。
为了保护这一古老物种,同样孕育成长于长江的三峡集团,展开了一场跨越40余年的生命接力。从子一代到子三代,从繁育放流到基因研究,从生境修复到江海追踪,科研人员在绝望的边缘守住了希望,用科技的力量为其打造了一艘“诺亚方舟”。
时间来到今年11月12日,首批全人工繁殖子三代中华鲟鱼苗在三峡坝区破膜而出,人工种群“自我造血”能力终于建立。此刻,中华鲟种群复兴的曙光开始出现。
破局:子三代“叩开”永续之门
初冬的湖北宜昌,江风凛冽,三峡坝区长江珍稀鱼类保育中心却涌动着热流。聚光灯下,培养皿中那些如同黑珍珠般的中华鲟鱼卵正在出苗。
▲正在出苗的子三代中华鲟鱼卵 摄影:杨津
“从子二代到子三代,这一步我们跨了16年。”三峡集团国家工程中心所属长江生物多样性研究中心(简称“生物多样性中心”)高级工程师郭柏福难掩激动。
长期以来,中华鲟保护者头顶悬着一把“达摩克利斯之剑”——种群老龄化。
数据显示,中华鲟人工种群子一代平均年龄已超17岁,预计在未来7至8年内将逐渐退出繁殖主力。如果不能在它们“退休”前,让子二代顺利接棒繁育出子三代,人工种群将面临“断档”危机。
“要想‘生’,必先‘熟’,如何让子二代性腺发育成熟,是赢得这场‘存续之战’的关键。”郭柏福说。
科研团队早在今年初就启动了严苛的“造鱼计划”。他们从数千尾子二代群体中优中选优,挑选出体格强健、发育良好的“种子选手”。
团队总结多年研究实践成果,通过精准调控光照、水流、水温和营养,在水池里复刻野生种群从大海洄游到长江繁育的时空转换过程,成功诱导子二代的感官体验,促使其性腺发育成熟。
11月6日,决定性的时刻到来。团队精准捕捉到了仅有短短几天的“黄金繁殖窗口”,对发育成熟的亲鱼实施人工催产。为了最大限度丰富遗传多样性,并确保受精率达到目标值,科研人员大胆创新,采取了“一雌两雄”的科学配对方案。
结果令人振奋:鱼卵受精率高达95%以上,经孵化获子三代鱼苗11.2万尾。
“子三代的诞生,证实了保有量更大的子二代中华鲟完全具备在人工环境下成熟并繁育后代的能力。”生物多样性中心副主任、中华鲟研究所总工程师姜伟表示,“自然生境的修复和野生种群的恢复都需要较长的周期,只有人工种群实现可持续的代际接力,才能帮助这一物种撑过‘濒危时间’。”
攀登:四十年“解锁”生命密码
中华鲟保护始于改革开放初期,面对当时国内环保意识、技术、人才、资金匮乏的现实,科研人员“白手起家”,关关难过关关过,用40余年时间织就起中华鲟保育技术体系。

▲上世纪90年代早期,科研人员在葛洲坝水电站下游放流人工繁育的子一代中华鲟。生物多样性中心供图
第一关,是“从无到有”的催产难关。
1982年,三三〇水产处(中华鲟研究所前身)成立,彼时行业内关于中华鲟人工繁殖技术几乎是一片空白。1984年,行业尝试用野生亲鱼繁殖子一代幼苗,但野生亲鱼在人工环境无法自然排卵,只能采用“杀鱼取卵”的方式进行繁殖研究。
“野生中华鲟数量已经在急剧下降,这样催产繁殖的成本太高了。”据郭柏福回忆,1986年,科研人员利用一种人工催产素——促黄体释放激素类似物(LRH-A)代替雄鱼脑垂体催产试验获得成功,从此不再需要为催产雌鱼牺牲雄鱼生命。随后,活体无创伤取卵技术也迎来突破。
第二关,是“子又生孙”的繁育难关。
中华鲟是典型的海河洄游鱼类,在大海里长大,回长江产卵。期间时空环境的变化,是诱发中华鲟性腺成熟的“自然密码”。而未见过江海的子一代,如何在水池里成熟并繁育?这在当时被认为是“违背自然规律”的难题。
科研人员在前期繁殖培育实践基础上,围绕与子一代成熟、繁殖相关的水温、光照、食物等因素,开展试验持续攻关,终于在2009年攻克这一难题。当年10月4日,第一尾全人工繁殖的子二代鱼苗破膜而出。这意味着,即使野外灭绝这一极端情况发生,人类也能在实验室里继续传递中华鲟的种群火种。
第三关,是“优生优育”的基因难关。
保种,不仅要保数量,更要保质量——保住物种最原始、最丰富的遗传信息。
“确保繁育质量,必须基于对物种的充分认知,这就要求我们的研究抵达基因层面。”据生物多样性中心副主任工程师杜合军介绍,2013年,科研团队启动中华鲟基因组研究,经过10年探索,于2023年成功完成了中华鲟八倍体全基因组测序,拿到了中华鲟的“生命字典”和“基因地图”。

▲中华鲟基因组组装序列图谱关键特征分布图 资料图片
基因层面的深入研究,使得科研人员能从基因层面进行亲鱼精准配对,避免近亲繁殖,更可剔除不良基因,筛选抗病强、生长快的个体,实现中华鲟的“优生优育”。
从杀鱼取卵到无创催产,从依赖野生到全人工繁殖,从传统养殖到基因研究。40多年走过,三峡集团不仅建成全球最大的中华鲟人工种群梯队,更为中华鲟搭建起一座集精子库、细胞库、组织库、基因库于一体的“超级种质资源库”,让这一濒危物种搭上“诺亚方舟”。
守望:从“救一条鱼”到“护一条江”
在三峡集团的生态账本里,保护中华鲟,从来不仅仅是为了保护一条鱼。

▲科研人员在长江口放流携带卫星标记的中华鲟,开展其海洋生活史研究。摄影:杨津
“中华鲟是长江生态系统的旗舰物种,也是‘吹哨鱼’。”姜伟解释道,“它跨越江海,如果能活得好,就意味着长江和近海的生态系统是健康的。”
因此,三峡集团的保护格局,从一开始就着眼于“江海全生境”和“水生朋友圈”。
一方面,这是从陆地到江海再到太空的立体守护。
保护一条洄游鱼类,必须守护它走过的每一公里——
在陆地,科研人员建设了国内最大的中华鲟保护基地,保育着规模最大的子二代中华鲟种群梯队;
在江中,他们持续监测并修复葛洲坝水电站下游自然产卵场,为野生中华鲟保留适宜的“产床”;
在海洋,他们利用声呐标记与卫星追踪技术,探索中华鲟神秘的海洋生活史。
通过“上天入海”的全方位研究保护,确保中华鲟不仅能“生得下来”,更能“回归长江,游向大海”。
另一方面,这是从旗舰物种到整个生物链的系统保护。
长江生物多样性的恢复,需要的是整个生物链的生机。
在长江上游,科研人员已掌握同为国家一级保护野生动物长江鲟的全人工繁殖技术,大规模增殖放流已持续开展多年;
在金沙江下游,三峡集团建立了乌东德、向家坝两个鱼类增殖放流站,成功攻克了圆口铜鱼、长鳍吻鮈、齐口裂腹鱼、岩原鲤等十余种珍稀特有鱼类的人工繁殖难题。其中,圆口铜鱼、长鳍吻鮈等高难度物种的繁育突破,更是填补了业内空白。
为了让“青草鲢鳙”四大家鱼繁衍生息,三峡集团连续多年实施梯级水库联合生态调度。每到繁殖季节,大坝精准调节下泄流量,形成模拟自然洪流的“人造洪峰”,为鱼类繁殖提供合适的水温、水流条件。监测数据显示,四大家鱼的繁殖规模已从几千万粒激增至数百亿粒。
当前,在中华鲟长期保护工作中积累的经验成果,正在惠及整个长江水生生物群落。中华鲟作为对环境要求极高的旗舰物种,攻克其繁育难题所提炼出的生物学本质和生态学逻辑,具有极强的普适性,对其他珍稀鱼类的保护提供了理论支撑和经验参考。
成果是显著的:40多年来,三峡集团已累计向长江放流中华鲟超过760万尾,放流其他珍稀特有鱼类超过2000万尾,加上生态调度对鱼类繁殖数量的大幅提升,长江鱼类资源库正在快速复苏。
“河水洋洋,北流活活。施罛濊濊,鳣鲔发发。”《诗经》中描绘的鲟鱼成群的壮丽景象,是中华民族千年的生态记忆。子三代的诞生,照亮了中华鲟种群复兴的漫长洄游路。三峡人的守望,依然在继续。
编辑:任贤 卢西奥
发布日期:2025年12月15日